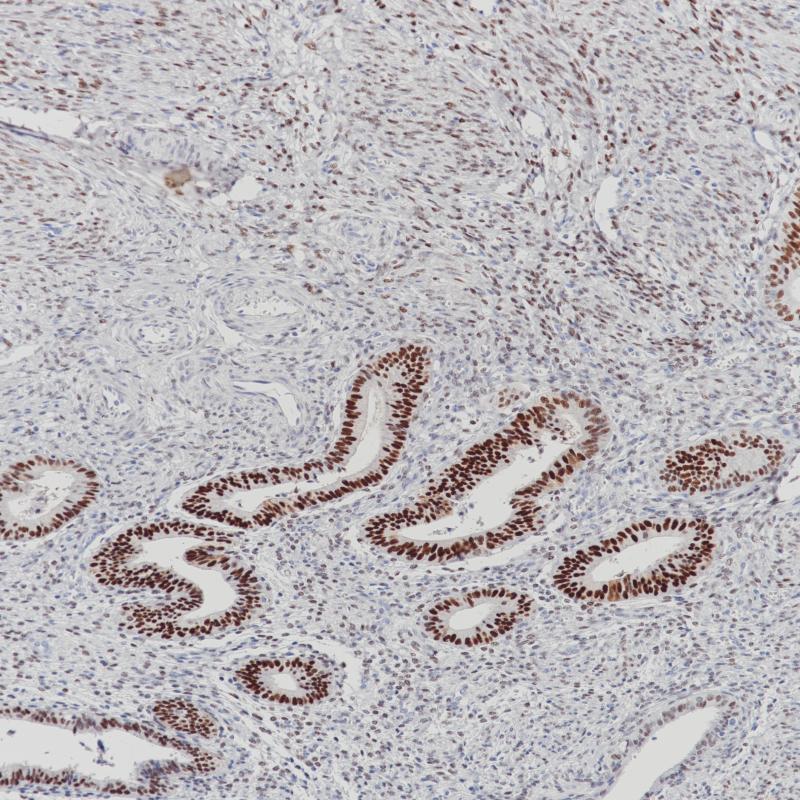

Breast Carcinoma
Endometrium
ER Recombinant Rabbit Monoclonal Antibody
Estrogen receptor (ER) belongs to the steroid receptor superfamily of nuclear receptors. It is a protein with 553 amino acids. The receptor molecule has three domains, i.e. the central DNA-binding domain, the hormone-binding domain at the C-terminal, and the transcription-activating domain at the N-terminal. ER mediates regulatory functions of female sex steroids, mainly 17 (E2), on growth, differentiation and function in several target tissues, including female and male reproductive tract, mammary gland, and skeletal and cardiovascular systems.
Studies have shown ER α is present in the nuclei of epithelial cells in normal breast and endometrial tissues, as well as a subset of breast carcinomas.
Studies with immunohistochemical assay show that positive steroid hormone status has predicted favourable overall, survival, independently of hormonal treatment. Secondly, ER α can be used as a tumour marker, preferentially in combination with an antibody to progesterone receptor, e.g., in the classification of adenocarcinomas.
Studies have shown ER α is present in the nuclei of epithelial cells in normal breast and endometrial tissues, as well as a subset of breast carcinomas.
Studies with immunohistochemical assay show that positive steroid hormone status has predicted favourable overall, survival, independently of hormonal treatment. Secondly, ER α can be used as a tumour marker, preferentially in combination with an antibody to progesterone receptor, e.g., in the classification of adenocarcinomas.
Specifications
- Catalog No.
- BX50135
- Clone No.
- BP6139
- Application
- IHC-P
- Subcellular location
- Nucleus
- Control
- Breast Carcinoma Tissue
- Recommended method
- HIER
- Volume
- 100μl/vial, 1ml/vial
- Dilution
- 1:100-1:200
- Immunogen
- Synthetic peptide corresponding to ER alpha residues within aa495‐595 of ER alpha was used as an immunogen.
Reference
1.Stein B, et.al, Mol Cell Biol. 1995 Sep;15(9):4971-9.
2.Saville B, et.al,J Biol Chem. 2000 Feb 25;275(8):5379-87.
Support Documents
Order
- E-mail : sales@biolynx.cn



